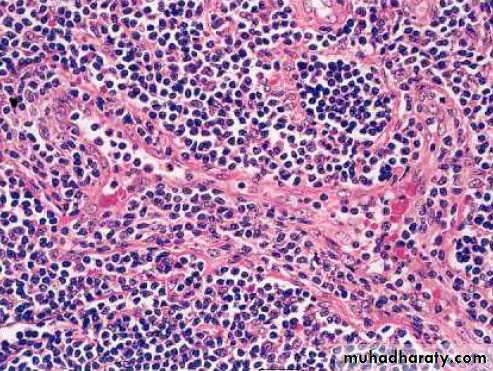
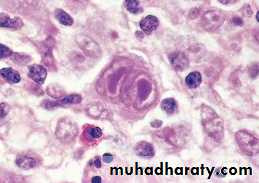

Lympho Reticular System
The lymphoreticular system is involved in the defence ofthe body against microorganisms and foreign substances –
i.e. the immune response.
Consists of :
Thymus ,Spleen ,
Lymph nodes ,
Mucosa Associated Lymphoid Tissue (MALT) in Gut and Upper respiratory tract ,
Bone Marrow.
Lympho Reticular System
Lymph node
Under normal conditions lymph nodes are small bean shaped structuresmajor peripheral locations (e.g. cervical, axillary or inguinal) are seldom palpable.
Their primary function is to entrap foreign agents or
unwanted materials & an immune response .
Lymphadenopathy
Lymph node enlargement is an important clinical finding.Acute Lymphadenitis
eitherFocal: usually direct drainage of infected areas
Generalized: viral, bacteremic, exotoxic diseases
Nodes: swollen, gray-red, engorged; large germinal centers
Neutrophils frequently present
Chronic Lymphadenitis
Follicular hyperplasiaB-Cells stimulated
Large germinal centers demarcated by mantle zone
Follicles vary in size and shape (vs lymphoma)
Follicular hyperplasia could be non-specific
Or due to specific causes;Toxoplasmosis, rheumatoid arithritis, SLE, AIDS
Diffuse (Paracortical) hyperplasia
Expansion of T-cell regions with effacement of folliclesOccur in viral infection (infectious mononucleosis), drug reaction (anticonvulsant)
Sinus Pattern of Hyperplasia
Sinus histiocytosis – a proliferation of histiocytes in the sinuses – is a common reaction most often seen in nodes draining malignant tumoursGranulomatous Pattern
These are lymphadenopathies that are characterizedby the presence of granulomas or localized aggregates
of histiocytes as the most prominent feature
T.B , toxoplasmosis, syphilis, sarcoidosis, fungal infection
SarcoidosisDiagnosis is always one of exclusion;
Lung (90%), LN’s, eyes, skin most commonly affected
Non-caseating granulomatous inflammation in nodes/skin,
with scattered Langhans’ giant cells
Necrosis is absent
Schaumann bodies, asteroid bodies, and calcium oxalate crystals in cytoplasm of giant cells; none are specific
Kveim test: 60-85%
Sarcoidosis: lymph node
Suppurative granulomas :
It is characterized by the presence of neutrophilis within the necrosis of granuloma, examples:Cat scratch disease; young patient with GLA, fever, exposed to pet animal.
Lymphogranuloma venerium : chlamydial infection , sexually transmitted disease mainly in adult males.
Yersienia pseudotubrculosis; in mesenteric nodes in young adults .Simulates appendicitis.
Malignant lymphoma
It is a primary tumor of lymphocytes , lead to lymphadenopathy (generalized or localized) ,30-40% extranodal.Hodgkin’s Lymphoma
Clinical features :it has a bimodal incidence with peaks in early adult life and in late middle age .
presents with enlargement of peripheral lymph nodes, Extranodal involvement is extremely rare and is usually due to direct extension from a nodal mass
There may be systemic symptoms, most notably an intermittent low-grade fever, sweating, weight loss and pruritus.
The extent of involvement by HL is defined by the Ann Arbor staging system.
Macroscopic Pathology
The affected lymph nodes are usually discrete and rubbery,but may be matted together.
They have a grey-pink cut surface, often with areas of necrosis. There may be dense bands of fibrous tissue around and within the node
Microscopically
the presence of a small population of large neoplastic cells, theHodgkin/Reed–Sternberg cell, and second a large population
of non-neoplastic inflammatory cells.
The WHO classification
Classical type:1. Nodular sclerosis
2. Mixed cellularity
3. Lymphocyte-rich
4. Lymphocyte depletion